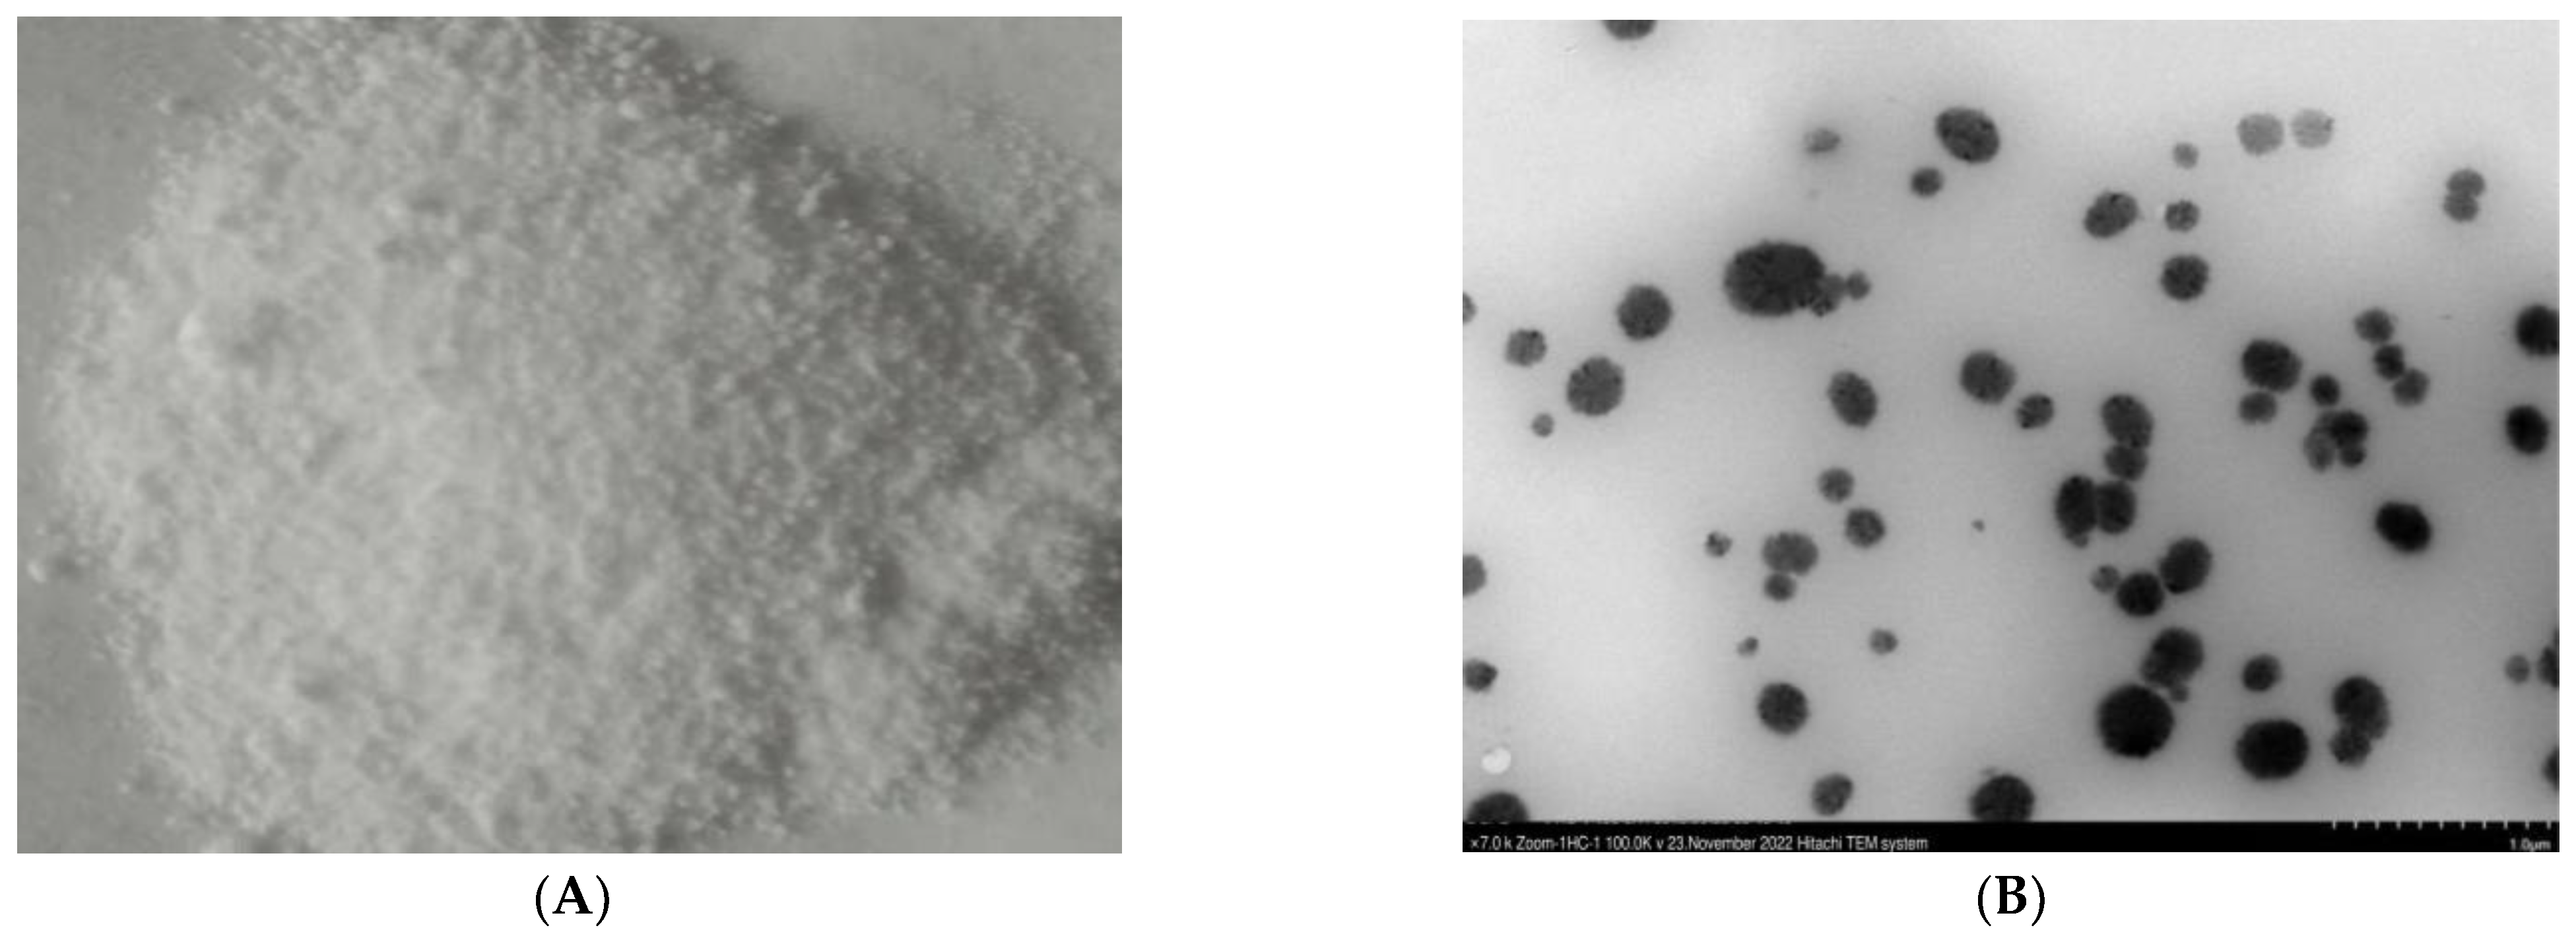
Ijms 24 02778 g002

Bio-Fabrication of ZnONPs from Alkalescent Nucleoside Antibiotic to Control Rice Blast: Impact on Pathogen (Magnaporthe grisea) and Host (Rice)
Abstract
:1. Introduction
2. Results
3. Discussion
4. Material and Methods
4.1. Microorganism
4.2. Separation, Purification, and Extraction of Alkalescent Nucleoside NA03 Antibiotic
4.3. Doskochilova Solvent System for the Confirmation of Alkalescent Nucleoside AN03
4.4. Bio-Fabrication of ZnONPs
4.5. Characterization of ZnONPs
4.6. In-Vitro Experiments
In-Vitro Antagonistic Assay of ZnONPs against M. grisea
4.7. Evaluating Morphological Alterations in Fungal Mycelia Using Scanning Electron Microscopy (SEM) and Transmission Electron Microscopy (TEM)
4.8. Reactive Oxygen Species (ROS) Assay
4.9. Green House Experiments
4.9.1. Growth Conditions
4.9.2. Disease Control Effects of ZnONPs against the M. grisea
4.9.3. Treatments to Determine the Impact of ZnONPs on Rice
4.9.4. Effects of ZnONPs on Rice Plant Growth Parameters
4.10. Statistical Analysis
5. Conclusions
Author Contributions
Funding
Institutional Review Board Statement
Informed Consent Statement
Data Availability Statement
Acknowledgments
Conflicts of Interest
References
- Asibi, A.E.; Chai, Q.; Coulter, J.A. Rice blast: A disease with implications for global food security. Agronomy 2019, 9, 451. [Google Scholar] [CrossRef]
- Shahriar, S.A.; Imtiaz, A.A.; Hossain, M.B.; Husna, A.; Khatun Eaty, N. Rice blast disease. Ann. Res. Rev. Biol. 2020, 35, 50–64. [Google Scholar] [CrossRef]
- Elmer, W.; White, J.C. The future of nanotechnology in plant pathology. Annu. Rev. Phytopathol. 2018, 56, 111–133. [Google Scholar] [CrossRef] [PubMed]
- Law, J.W.F.; Ser, H.L.; Khan, T.M.; Chuah, L.-H.; Pusparajah, P.; Chan, K.-G.; Goh, B.-H.; Lee, L.-H. The potential of streptomyces as biocontrol agents against the rice blast fungus, Magnaporthe oryzae (Pyricularia oryzae). Front. Microbiol. 2017, 8, 3. [Google Scholar] [CrossRef]
- Newitt, J.; Prudence, S.; Hutchings, M.; Worsley, S. Biocontrol of cereal crop diseases using streptomycetes. Pathogens 2019, 8, 78. [Google Scholar] [CrossRef] [PubMed]
- Ahsan, T.; Liu, H.; Shan, Y.H.; Zhou, T.; Ahmed, M.; Li, B.; Wu, Y. Identification and bio-control activity of Streptomyces strain (Koyanogensis) against Magnaporthegrisea. Biotechnol. Biotechnol. Equip. 2021, 35, 1891–1898. [Google Scholar] [CrossRef]
- Bonaterra, A.; Badosa, E.; Daranas, N.; Francés, J.; Roselló, G.; Montesinos, E. Bacteria as Biological Control Agents of Plant Diseases. Microorganisms 2022, 10, 1759. [Google Scholar] [CrossRef]
- Bejarano, A.; Puopolo, G. Bioformulation of microbial biocontrol agents for a sustainable agriculture. In How Research Can Stimulate the Development of Commercial Biological Control against Plant Diseases; De Cal, A., Melgarejo, P., Magan, N., Eds.; Progress in Biological Control; Springer: Cham, Switzerland, 2020; Volume 21, pp. 275–290. [Google Scholar]
- Kunova, A.; Palazzolo, L.; Forlani, F.; Catinella, G.; Musso, L.; Cortesi, P.; Eberini, I.; Pinto, A.; Dallavalle, S. Structural Investigation and Molecular Modeling Studies of Strobilurin-Based Fungicides Active against the Rice Blast Pathogen Pyricularia oryzae. Int. J. Mol. Sci. 2021, 22, 3731. [Google Scholar] [CrossRef]
- Rikta, S.Y.; Rajiv, P. Applications of silver nanomaterial in agricultural pest control. In Silver Nanomaterials for Agri-Food Applications; Elsevier: Amsterdam, The Netherlands, 2021; pp. 453–470. [Google Scholar]
- Shahcheraghi, N.; Golchin, H.; Sadri, Z.; Tabari, Y.; Borhanifar, F.; Makani, S. Nano-biotechnology, an applicable approach for sustainable future. 3 Biotech 2022, 12, 65. [Google Scholar] [CrossRef]
- Ahmad, A.; Mukherjee, P.; Senapati, S.; Mandal, D.; Khan, M.I.; Kumar, R.; Sastry, M. Extracellular biosynthesis of silver nanoparticles using the fungus Fusarium oxysporum. Colloids Surf. B Biointerfaces 2003, 28, 313–318. [Google Scholar] [CrossRef]
- Kakati, M.; Das, D.; Das, P.; Sanjeev, A.; Kumar, V.S. Effect of ethanol as molecular crowding agent on the conformational dynamics of α-synuclein. Lett. Appl. Nanobiosci. 2014, 9, 779–783. [Google Scholar]
- Rehana, D.; Mahendiran, D.; Kumar, R.S.; Rahiman, A.K. In vitro antioxidant and antidiabetic activities of zinc oxide nanoparticles synthesized using different plant extracts. Bioprocess Biosyst. Eng. 2017, 40, 943–957. [Google Scholar] [CrossRef] [PubMed]
- Sheikh, S.; Mungole, A.J.; Krambe, S. A Review on Plant Extract Mediated Biological Synthesis of Zinc Oxide Nanoparticles and Its Antimicrobial Applications. Int. J. Res. Biosci. Agric. Technol. 2022, 2, 286–289. [Google Scholar]
- Kahsay, M.H.; RamaDevi, D.; Kumar, Y.P.; Mohan, B.S.; Tadesse, A.; Battu, G.; Basavaiah, K. Synthesis of silver nanoparticles using aqueous extract of Dolichos lablab for reduction of 4-Nitrophenol, antimicrobial and anticancer activities. OpenNano 2018, 3, 28–37. [Google Scholar] [CrossRef]
- Hamida, R.S.; Ali, M.A.; Abdelmeguid, N.E.; Al-Zaban, M.I.; Baz, L.; Bin-Meferij, M.M. Lichens—A Potential Source for Nanoparticles Fabrication: A Review onNanoparticles Biosynthesis and Their Prospective Applications. J. Fungi 2021, 7, 291. [Google Scholar] [CrossRef]
- Fagier, M.A. Plant-Mediated Biosynthesis and Photocatalysis Activities of Zinc Oxide Nanoparticles: A Prospect towards Dyes Mineralization. J. Nanotechnol. 2021, 2021, e6629180. [Google Scholar] [CrossRef]
- Siddique, K.; Shahid, M.; Shahzad, T.; Mahmood, F.; Nadeem, H.; Saif ur Rehman, M.; Hussain, S.; Sadak, O.; Gunasekaran, S.; Kamal, T.; et al. Comparative Efficacy of Biogenic Zinc Oxide Nanoparticles Synthesized by Pseudochrobactrum sp. C5 and Chemically Synthesized Zinc Oxide Nanoparticles for Catalytic Degradation of Dyes and Wastewater Treatment. Environ. Sci. Pollut. Res. 2021, 28, 28307–28318. [Google Scholar] [CrossRef]
- Díaz-Cruz, G.A.; Liu, J.; Tahlan, K.; Bignell, D.R.D. Nigericin and Geldanamycin Are Phytotoxic Specialized Metabolites Produced by the Plant Pathogen Streptomyces sp. 11-1-2. Microbiol. Spectr. 2022, 10, e0231421. [Google Scholar] [CrossRef]
- Zhang, M.; Kong, L.; Gong, R.; Iorio, M.; Donadio, S.; Deng, Z.; Sosio, M.; Chen, W. Biosynthesis of C-nucleoside antibiotics in actinobacteria: Recent advances and future developments. Microb. Cell Fact 2022, 21, 2. [Google Scholar] [CrossRef]
- Palmu, K.; Rosenqvist, P.; Thapa, K.; Ilina, Y.; Siitonen, V.; Baral, B.; Mäkinen, J.; Belogurov, G.; Virta, P.; Niemi, J.; et al. Discovery of the Showdomycin Gene Cluster from Streptomyces showdoensis ATCC 15227 Yields Insight into the Biosynthetic Logic of C-Nucleoside Antibiotics. ACS Chem. Biol. 2017, 12, 1472–1477. [Google Scholar] [CrossRef]
- Niu, G.; Tan, H. Nucleoside antibiotics: Biosynthesis, regulation, and biotechnology. Trends Microbiol. 2015, 23, 110–119. [Google Scholar] [CrossRef] [PubMed]
- Chen, W.; Qi, J.; Wu, P.; Wan, D.; Liu, J.; Feng, X.; Deng, Z. Natural and engineered biosynthesis of nucleoside antibiotics in Actinomycetes. J. Ind. Microbiol. Biotechnol. 2016, 43, 401–417. [Google Scholar] [CrossRef] [PubMed]
- He, L.; Liu, Y.; Mustapha, A.; Lin, M. Antifungal activity of zinc oxide nanoparticles against Botrytis cinerea and Penicillium expansum. Microbiol. Res. 2011, 166, 207–215. [Google Scholar] [CrossRef] [PubMed]
- Lakshmeesha, T.R.; Murali, M.; Ansari, M.A.; Udayashankar, A.C.; Alzohairy, M.A.; Almatroudi, A.; Alomary, M.N.; Asiri, S.M.M.; Ashwini, B.S.; Kalagatur, N.K.; et al. Biofabrication of zinc oxide nanoparticles from Melia azedarach and its potential in controlling soybean seed-borne phytopathogenic fungi. Saudi J. Biol. Sci. 2020, 27, 1923–1930. [Google Scholar] [CrossRef] [PubMed]
- Arciniegas-Grijalba, P.A.; Patiño-Portela, M.C.; Mosquera-Sánchez, L.P.; Guerrero-Vargas, J.A.; Rodríguez-Páez, J.E. ZnO nanoparticles (ZnO-NPs) and their antifungal activity against coffee fungus Erythricium salmonicolor. Appl. Nanosci. 2017, 7, 225–241. [Google Scholar] [CrossRef]
- Jadoun, S.; Chauhan, N.P.S.; Zarrintaj, P.; Barani, M.; Varma, R.S. Nanomaterials for Sustainability: A Review on Green Synthesis of Nanoparticles Using Microorganisms. Environ. Chem. Lett. 2022. [Google Scholar] [CrossRef]
- Ahmed, T.; Wu, Z.; Jiang, H.; Luo, J.; Noman, M.; Shahid, M.; Manzoor, I.; Allemailem, K.S.; Alrumaihi, F.; Li, B. Bioinspired Green Synthesis of Zinc Oxide Nanoparticles from a Native Bacillus cereus Strain RNT6: Characterization and Antibacterial Activity against Rice Panicle Blight Pathogens Burkholderia glumae and B. gladioli. Nanomaterials 2021, 11, 884. [Google Scholar] [CrossRef]
- Faisal, S.; Abdullah; Rizwan, M.; Ullah, R.; Alotaibi, A.; Khattak, A.; Bibi, N.; Idrees, M. Paraclostridium Benzoelyticum Bacterium-Mediated Zinc Oxide Nanoparticles and Their In Vivo Multiple Biological Applications. Oxid. Med. Cell. Longev. 2022, 2022, e5994033. [Google Scholar] [CrossRef]
- Saleh, H.A.; Matter, I.A.; Abdel-Wareth, M.T.A.; Darwesh, O.M. Molluscicidal, Histopathological and Genotoxic Effects of Scenedesmus obliquus and Spirulina platensis Extracts and Their Biosynthesized Zinc Oxide Nanoparticles on Biomphalaria alexandrina Snails. Aquac. Res. 2022, 53, 3680–3695. [Google Scholar] [CrossRef]
- Sun, L.; Zhou, R.; Sui, J.; Liu, Y. Simultaneous Preparation of Salidroside and p-Tyrosol from Rhodiola crenulata by DIAION HP-20 Macroporous Resin Chromatography Combined with Silica Gel Chromatography. Molecules 2018, 23, 1602. [Google Scholar] [CrossRef]
- Shirshekanb, M.; Rezadoost, H.; Javanbakht, M.; Ghassempour, A.R. The Combination Process for Preparative Separation and Purification of Paclitaxel and 10-Deacetylbaccatin III Using Diaion® Hp-20 Followed by Hydrophilic Interaction Based Solid Phase Extraction. Iran J. Pharm. Res. 2017, 16, 1396–1404. [Google Scholar]
- Ministry of Agriculture of the People’s Republic of China. Guidelines on Effificacy Evaluation of Pesticides, Part 15: Fungicides against Fusarium Head Blight of Wheat; NY/T 1464.15-2007; China Agriculture Press: Beijing, China, 2007.
- Sundrarajan, M.; Ambika, S.; Bharathi, K. Plant-extract mediated synthesis of ZnO nanoparticles using Pongamia pinnata and their activity against pathogenic bacteria. Adv. Powder Technol. 2015, 26, 1294–1299. [Google Scholar] [CrossRef]
- Barzinjy, A.A.; Azeez, H.H. Green synthesis and characterization of zinc oxide nanoparticles using Eucalyptus globulus Labill. leaf extract and zinc nitrate hexahydrate salt. SN Appl. Sci. 2020, 2, 991. [Google Scholar] [CrossRef]
- Jayaseelan, C.; Rahuman, A.A.; Kirthi, A.V.; Marimuthu, S.; Santhoshkumar, T.; Bagavan, A.; Gaurav, K.; Karthik, L.; Bhaskar Rao, K.V. Novel microbial route to synthesize ZnO nanoparticles using Aeromonas hydrophila and their activity against pathogenic bacteria and fungi. Spectrochim. Acta A Mol. Biomol. Spectrosc. 2012, 90, 78–84. [Google Scholar] [CrossRef]
- Hassan, S.E.; Fouda, A.; Radwan, A.A.; Salem, S.S.; Barghoth, M.G.; Awad, M.A.; Abdo, A.M.; El-Gamal, M.S. Endophytic actinomycetes Streptomyces spp mediated biosynthesis of copper oxide nanoparticles as a promising tool for biotechnological applications. J. Biol. Inorg. Chem. 2019, 24, 377–393. [Google Scholar] [CrossRef]
- Jayarambabu, N.; Kumari, B.S.; Rao, K.V.; Prabhu, Y. Beneficial role of zinc oxide nanoparticles on green crop production. Int. J. Multidiscip. Adv. Res. Trends 2015, 2, 273–282. [Google Scholar]
- Punjabi, K.; Mehta, S.; Chavan, R.; Chitalia, V.; Deogharkar, D.; Deshpande, S. Efficiency of Biosynthesized Silver and Zinc Nanoparticles against Multi-Drug Resistant Pathogens. Front. Microbiol. 2018, 9, 2207. [Google Scholar] [CrossRef]
- Chen, J.; Sun, L.; Cheng, Y.; Lu, Z.; Shao, K.; Li, T.; Hu, C.; Han, H. Graphene oxide-silver nanocomposite: Novel agricultural antifungal agent against fusarium graminearum for crop disease prevention. ACS Appl. Mater. Interfaces 2016, 8, 24057–24070. [Google Scholar] [CrossRef] [PubMed]
- Khan, M.R.; Siddiqui, Z.A. Role of Zinc Oxide Nanoparticles in the Management of Disease Complex of Beetroot (Beta vulgaris L.) Caused by Pectobacterium betavasculorum, Meloidogyne incognita and Rhizoctonia solani. Hortic. Environ. Biotechnol. 2021, 62, 225–241. [Google Scholar] [CrossRef]
- Chattha, M.U.; Amjad, T.; Khan, I.; Nawaz, M.; Ali, M.; Chattha, M.B.; Ali, H.M.; Ghareeb, R.Y.; Abdelsalam, N.R.; Azmat, S.; et al. Mulberry based zinc nano-particles mitigate salinity induced toxic effects and improve the grain yield and zinc bio-fortification of wheat by improving antioxidant activities, photosynthetic performance, and accumulation of osmolytes and hormones. Front. Plant Sci. 2022, 13, 920570. [Google Scholar] [CrossRef]
- Lv, B.S.; Li, X.W.; Ma, H.Y.; Sun, Y.; Wei, L.X.; Jiang, C.J.; Liang, Z.W. Differences in growth and physiology of rice in response to different saline-alkaline stress factors. Agron. J. 2013, 105, 1119–1128. [Google Scholar] [CrossRef]
- Vincent, J.G.; Vincent, H.W.; Morton, J. Filter Paper Disc Modification of the Oxford Cup Penicillin Determination. Proc. Soc. Exp. Biol. Med. 1944, 55, 162–164. [Google Scholar] [CrossRef]

| Treatment | Mean ± SE | ||||
|---|---|---|---|---|---|
| Plant Height (cm) | Root Length (cm) | Number of Tillers (n) | Weight of Fresh Plant (g) | Weight of Dry Plants (g) | |
| Inoculated with M. grisea | 42.33 ± 1.33 d | 4.33 ± 0.33 c | 3.00 ± 0.58 b | 48.33 ± 3.33 c | 37.17 ± 1.59 c |
| ZnONPs + Inoculated with M. grisea | 63.00 ± 0.58 b | 7.33 ± 0.88 b | 4.00 ± 0.58 ab | 63.00 ± 3.51 b | 48.57 ± 4.30 b |
| ZnONPs | 72.33 ± 2.40 a | 12.33 ± 0.33 a | 5.33 ± 0.67 a | 99.00 ± 5.86 a | 83.00 ± 3.51 a |
| CK | 55.00 ± 2.08 c | 8.00 ± 0.58 b | 4.00 ± 0.58 ab | 64.33 ± 2.91 b | 39.00 ± 3.21 bc |
Disclaimer/Publisher’s Note: The statements, opinions and data contained in all publications are solely those of the individual author(s) and contributor(s) and not of MDPI and/or the editor(s). MDPI and/or the editor(s) disclaim responsibility for any injury to people or property resulting from any ideas, methods, instructions or products referred to in the content. |
© 2023 by the authors. Licensee MDPI, Basel, Switzerland. This article is an open access article distributed under the terms and conditions of the Creative Commons Attribution (CC BY) license (https://creativecommons.org/licenses/by/4.0/).
Share and Cite
Ahsan, T.; Li, B.; Wu, Y.; Li, Z. Bio-Fabrication of ZnONPs from Alkalescent Nucleoside Antibiotic to Control Rice Blast: Impact on Pathogen (Magnaporthe grisea) and Host (Rice). Int. J. Mol. Sci. 2023, 24, 2778. https://doi.org/10.3390/ijms24032778
Ahsan T, Li B, Wu Y, Li Z. Bio-Fabrication of ZnONPs from Alkalescent Nucleoside Antibiotic to Control Rice Blast: Impact on Pathogen (Magnaporthe grisea) and Host (Rice). International Journal of Molecular Sciences. 2023; 24(3):2778. https://doi.org/10.3390/ijms24032778
Chicago/Turabian StyleAhsan, Taswar, Bingxue Li, Yuanhua Wu, and Zijing Li. 2023. "Bio-Fabrication of ZnONPs from Alkalescent Nucleoside Antibiotic to Control Rice Blast: Impact on Pathogen (Magnaporthe grisea) and Host (Rice)" International Journal of Molecular Sciences 24, no. 3: 2778. https://doi.org/10.3390/ijms24032778
APA StyleAhsan, T., Li, B., Wu, Y., & Li, Z. (2023). Bio-Fabrication of ZnONPs from Alkalescent Nucleoside Antibiotic to Control Rice Blast: Impact on Pathogen (Magnaporthe grisea) and Host (Rice). International Journal of Molecular Sciences, 24(3), 2778. https://doi.org/10.3390/ijms24032778








